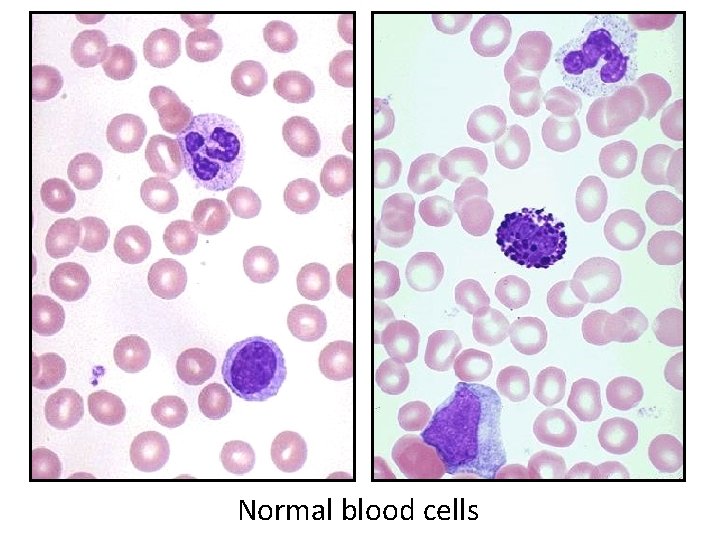
Normal blood cells
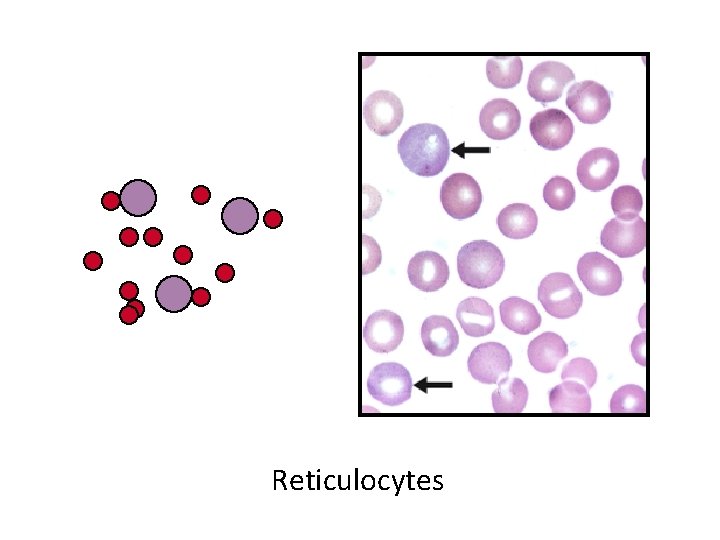
Reticulocytes
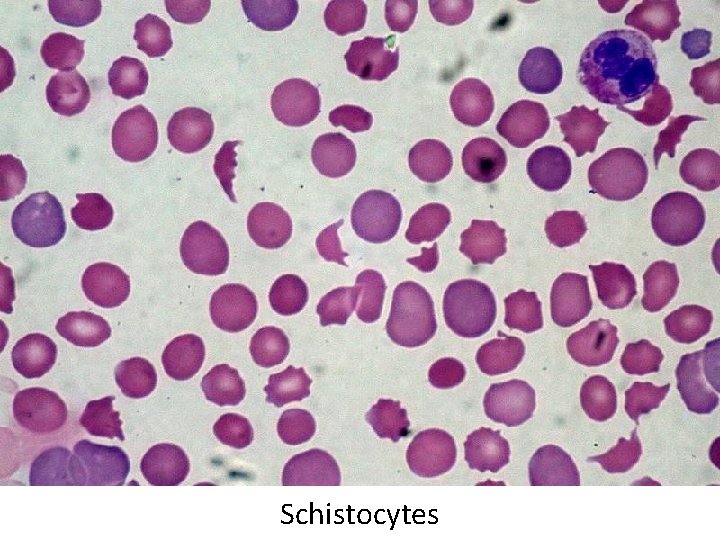
Schistocytes
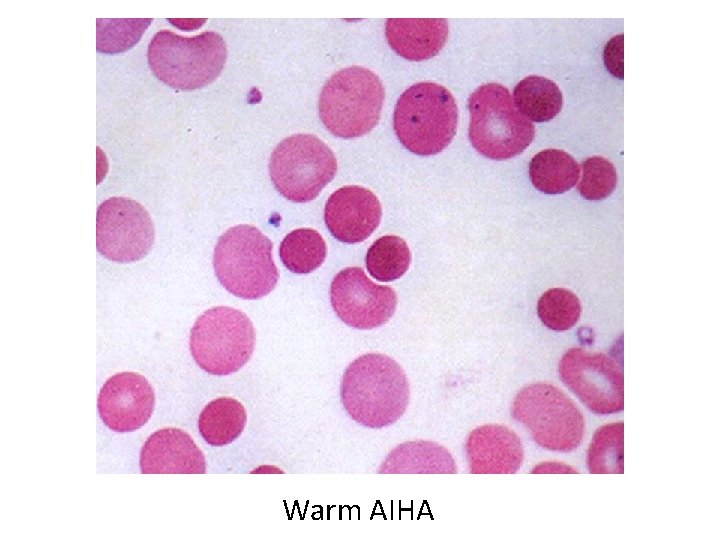
Warm AIHA
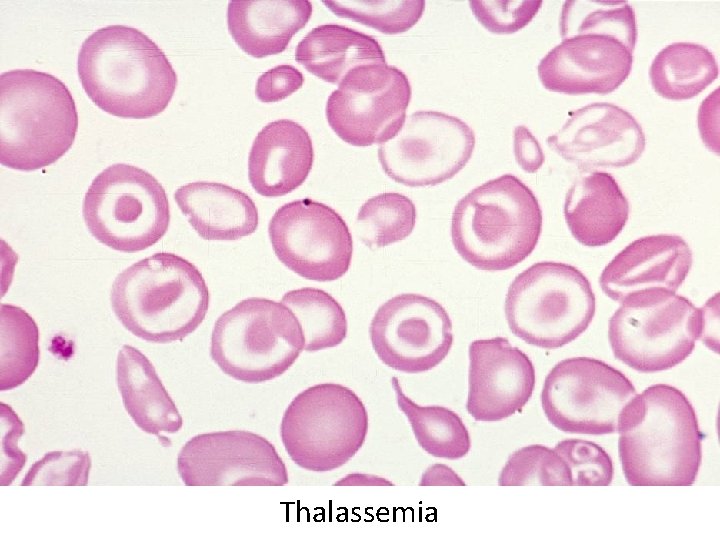
Thalassemia
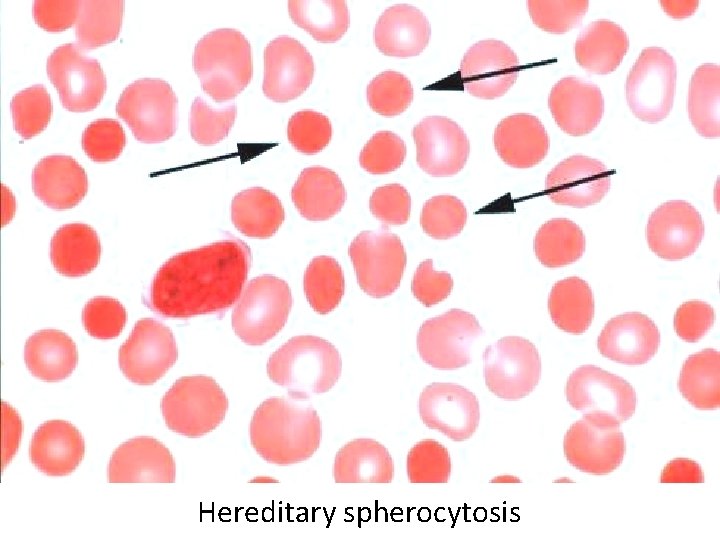
Hereditary spherocytosis
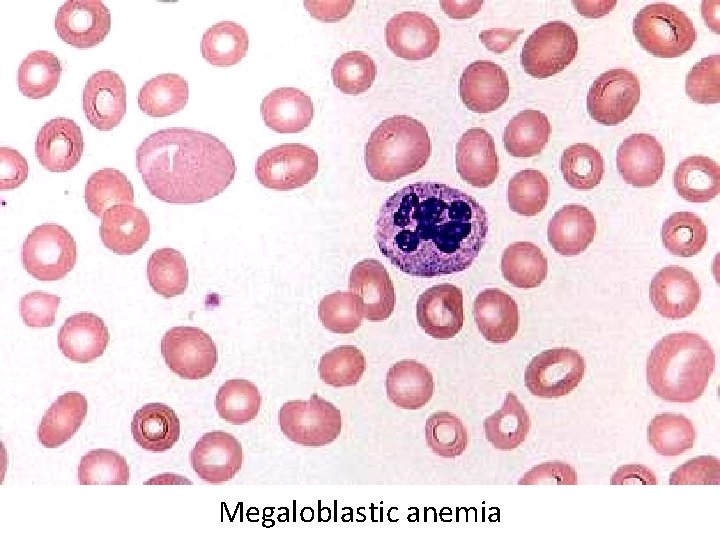
Megaloblastic anemia
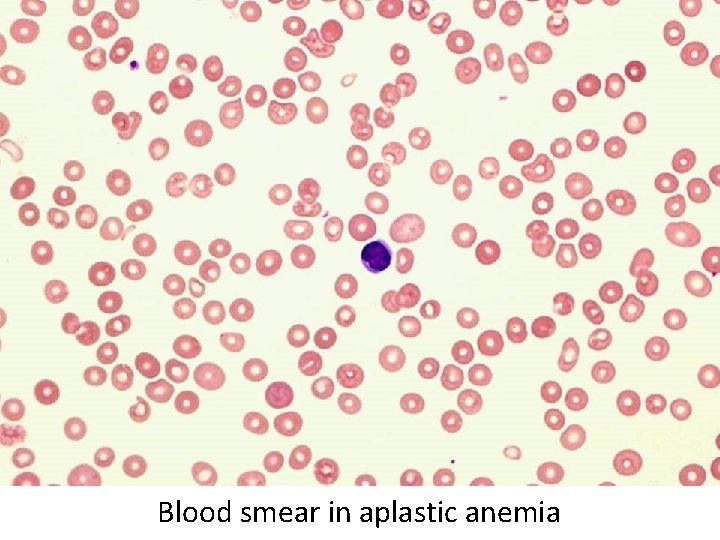
Blood smear in aplastic anemia

Anemia Kristine Krafts M D Anemia Outline Background

Anemia Kristine Krafts, M. D.

Anemia Outline • Background facts about blood • Anemia: general information • Anemia: specific types

Anemia Outline • Background facts about blood
Normal blood cells


Complete Blood Count (CBC) RBC Hemoglobin Hematocrit

Complete Blood Count (CBC) MCV microcytic normocytic MCHC macrocytic hypochromic normochromic

Additional Red Blood Cell Properties Size variation Shape anisocytosis poikilocytosis

Normal red blood cells

Anemia Outline • Background facts about blood • Anemia: general information

An (without) -emia (blood): a reduction below normal in hemoglobin or red blood cell number.

Symptoms of Anemia Pale skin, mucous membranes Jaundice (if hemolytic) Tachycardia Breathlessness Dizziness Fatigue

Anemia Outline • Background facts about blood • Anemia: general information • Anemia: specific types

Three Ways to Get Anemic Lose blood Destroy too much blood • Extracorpuscular reasons • Intracorpuscular reasons Make too little blood • Too few building blocks • Too few erythroblasts • Not enough room

Three Ways to Get Anemic Lose blood

Anemia of Blood Loss Things you must know • Cause: traumatic, acute blood loss • At first, hemoglobin is normal! • After 2 -3 days, see reticulocytes • Chronic blood loss is different (it causes iron deficiency anemia).
Reticulocytes

Three Ways to Get Anemic Lose blood Destroy too much blood • Extracorpuscular reasons • Intracorpuscular reasons

Hemolytic Anemias • Intracorpuscular vs. extracorpuscular • Chronic vs. acute • Signs of destruction: ↑ bilirubin, ↑ LDH, ↓ haptoglobin • Signs of production: ↑ reticulocytes, nucleated red cells in blood

Reticulocytes (supravital stain)

Three Ways to Get Anemic Lose blood Destroy too much blood • Extracorpuscular reasons

Microangiopathic Hemolytic Anemia Things You Must Know • Physical trauma to red cells • Schistocytes • Find out why!

Red cells snagged on fibrin strand
Schistocytes

Triangulocyte

Causes of MAHA • Artificial heart valve • Malignancy • Obstetric complications • Sepsis • Trauma

Autoimmune Hemolytic Anemia Things You Must Know • Warm AIHA • Ig. G • Spleen • Spherocytes • Cold AIHA • Ig. M, complement • Intravascular hemolysis • Agglutination

Warm AIHA

Warm AIHA
Warm AIHA

Cold AIHA

Cold AIHA

patient red cells + AHG = agglutination Direct antiglobulin test (DAT)

Three Ways to Get Anemic Lose blood Destroy too much blood • Extracorpuscular reasons • Intracorpuscular reasons

Sickle Cell Anemia Things You Must Know • Hemoglobinopathy (qualitative defect in hemoglobin) • Single amino acid substitution in beta chain of hemoglobin • Can be heterozygous or homozygous • Sickle cells are nasty: • Fragile (burst easily) • Get stuck in vessels

Hemoglobin

Point mutation in chain gene abnormal chains (substitution of valine for glutamate) Hgb S Nasty! Aggregates and polymerizes on deoxygenation Red cell becomes sickle shaped Sickles clog up vessels… …plus, they are fragile

Sickle cell anemia


Sickle cell anemia: foot lesion

Sickle cell anemia: spleen

Clinical Findings in Sickle Cell Anemia • Blacks (8% are heterozygous) • Severity of disease is variable • Chronic hemolysis, vaso-occlusive disease, and infections (autosplenectomy) • Treatment: prevent triggers, vaccinate, transfuse

Thalassemia Things You Must Know • Quantitative defect in hemoglobin • Can’t make enough α or β chains • Variable disease severity • Hypochromic, microcytic anemia with increased RBC and target cells

α β γ δ birth Hgb F = α 2γ 2 Hgb A 2 = α 2δ 2 Hgb A = α 2β 2 Hemoglobin chain development
Thalassemia

Thalassemia: Medullary expansion

Hereditary Spherocytosis Things You Must Know • Tons of spherocytes • Spectrin defect • Splenectomy is curative

z
Hereditary spherocytosis

Splenomegaly in hereditary spherocytosis

Glucose-6 -Phosphate Dehydrogenase Deficiency Things You Must Know • G 6 PD → peroxides → cell lysis • Oxidant exposure • Bite cells (removal of Heinz bodies) • Self-limiting

Clinical Findings in G 6 PD Deficiency • Some patients asymptomatic • Others have episodic hemolysis • Triggers: broad beans (favism), drugs (antibiotics, aspirin) • Spontaneous resolution

Child with G 6 PD deficiency: jaundiced sclera


Why Do G 6 PD-Deficient Red Cells Die? • They can’t reduce nasties • Nasties attack hemoglobin bonds • Heme breaks away from globin • Globin denatures, sticks to red cell membrane (“Heinz body”) • Spleen bites out Heinz bodies

G 6 PD deficiency: Heinz bodies

G 6 PD deficiency: bite cells

Three Ways to Get Anemic Lose blood Destroy too much blood • Extracorpuscular reasons • Intracorpuscular reasons Make too little blood • Too few building blocks

Iron-Deficiency Anemia Things You Must Know • Most important cause: GI bleeding • Microcytic, hypochromic anemia • Must find out why patient is iron deficient!

Hemoglobin

Iron-deficiency anemia

Atrophic glossitis in iron-deficiency anemia

Koilonychia in iron-deficiency anemia

Causes of Iron Deficiency • Decreased iron intake • bad diet • bad absorption • Increased iron loss • GI bleed • menses • hemorrhage • Increased iron requirement • pregnancy

Anemia of Chronic Disease Things You Must Know • Infections, inflammation, malignancy • Iron metabolism disturbed • Normochromic, normocytic anemia • Anemia usually mild

Megaloblastic Anemia Things You Must Know • Defective DNA synthesis • Nuclear/cytoplasmic asynchrony • B 12/folate • Macrocytic anemia with oval macrocytes and hypersegmented neutrophils

methyl FH 4 B 12 FH 4 methylene FH 4 FH 2 d. UMP d. TMP Need B 12 to make DNA! DNA

Megaloblastic Anemia retarded DNA synthesis unimpaired RNA synthesis BIG cells! immature nucleus mature cytoplasm
Megaloblastic anemia

Megaloblastic anemia

Atrophic glossitis in megaloblastic anemia

What else is B 12 good for? homocysteine methionine endothelial damage myelin damage atherosclerosis thrombosis subacute combined degeneration

Three Ways to Get Anemic Lose blood Destroy too much blood • Extracorpuscular reasons • Intracorpuscular reasons Make too little blood • Too few building blocks • Too few erythroblasts

Aplastic Anemia Things You Must Know • Pancytopenia • Empty marrow • Most are idiopathic
Blood smear in aplastic anemia

Empty bone marrow in aplastic anemia

Empty bone marrow in aplastic anemia

Causes of Aplastic Anemia • Idiopathic • Drugs • Viruses • Pregnancy • Fanconi anemia

Three Ways to Get Anemic Lose blood Destroy too much blood • Extracorpuscular reasons • Intracorpuscular reasons Make too little blood • Too few building blocks • Too few erythroblasts • Not enough room

Bone marrow full of fibrosis
- Slides: 80